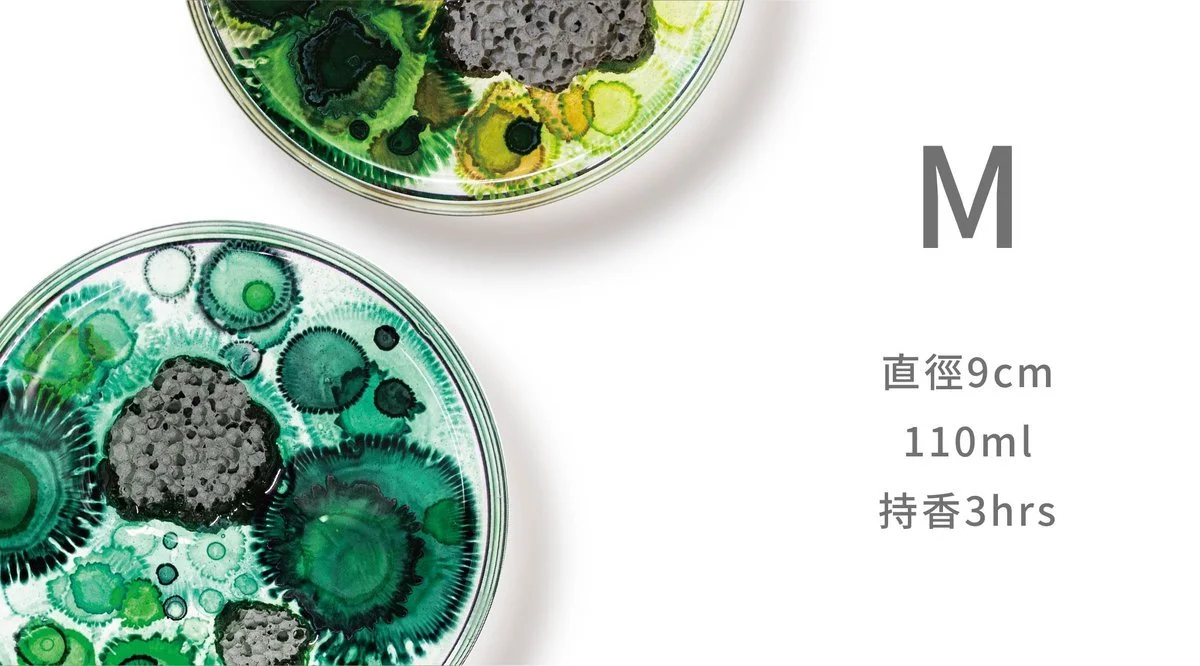

[ 氣味培養皿 The New Normal|淨化環境的嗅覺實驗 ]
創意 X 家飾 X 香氛 X 永續
後疫情時代,回歸生命與自然的體悟,重新感知的「新常態 ( The New Normal )」。
WASTE將實驗室中的微觀世界轉化成一件件獨一無二的藝術品,以氣味的情感連結和集體意識作為匯集與整合後關於「The New Normal」的抽象意象,讓你我創造自我空間的想像。
In the post-epidemic era, the COVID-19 epidemic has not only affected the international political system and economy, but also regulated the "new distance" between people. However, in the decadence like the last days, there is still a "shimmer"; while social and economic activities have been drastically reduced, the epidemic has also eased the ecological burden and given the earth to breathe. Mankind should take this opportunity to re-examine the "normal" that the world needs, stop expanding and encroaching upon nature, and work together to maintain various positive effects. The optimization of human adaptability and how the "new normal" produced by the deduction back and forth should be applied and continued is a goal that we need to think about and challenge after the epidemic.
The existence of "shimmer" reminds us that at the back of the crisis, can human beings remember to grasp the hidden changes, opportunities and revelations.
[ 產品特色 ]
●三種尺寸,裝飾空間新選擇
●多種配色,每一件都是獨一無二的藝術品
●全新綠能擴香, WASTE以春池玻璃研發的科技綠能建材作為擴香載體。
●操作簡易,滴入幾滴擴香淨油即可讓香氣充滿空間
[ 產品品項 ]
Small 最方便
直徑6cm|35ml | 持香2hrs
Medium 最百搭
直徑9cm|110ml | 持香3hrs
Large 最矚目
直徑11.5cm|140ml | 持香5hrs
▲三種尺寸的規格比較圖,可依照想擺放的空間做對照。
[ 報導連結 ]
dpi插畫設計誌 https://www.dpi.media/article/25259
大人物 https://www.damanwoo.com/node/94942
Vogue https://reurl.cc/E2Ng50
群眾觀點 http://crowdwatch.tw/post/26106/
中時新聞網 https://reurl.cc/GdYRDx
經濟日報 https://money.udn.com/money/story/11799/5372362
Everyday Object https://reurl.cc/a5zgK4
Shopping Design https://reurl.cc/o9X6EM
▌關於WASTE
質物霽畫主理人李霽於 2021 創立了全新的家具品牌《WASTE》,藉由產業之間彼此串連的運作機制,將建設產業、時尚產業、科技術與實驗機構等不同領域的廢棄物進⾏收集以及整理,貫徹的品牌核心——解決當今過多廢棄物與環境產生的負荷,透過了解材料的本質,賦予其新的價值和功能性;並透過美學的再現,找到屬於未來環境的混合性設計語言。
如欲購買產品歡迎私訊或透過MAIL聯繫我們: info@bvlc.world